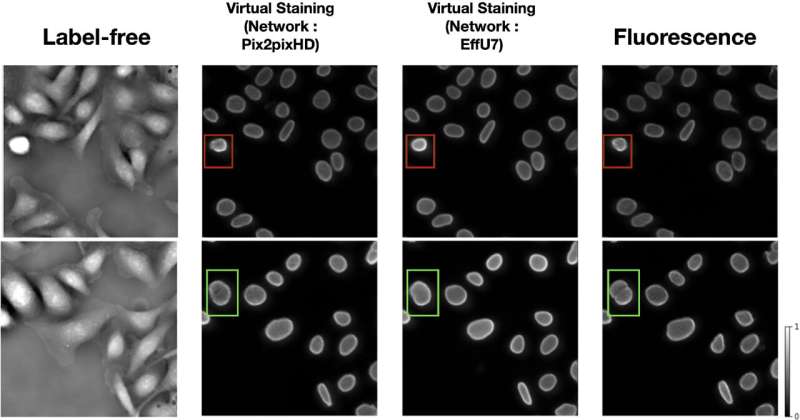

Лента новостей → Метод ИИ для обработки медицинских изображений
Выглядеть хорошо — это ещё не всё: исследователи оценивают метод ИИ для обработки медицинских изображений

Обзор рабочего процесса исследования и стратегии оценки эффективности задач. (a) Общая схема виртуального окрашивания. Эти виртуально окрашенные изображения были получены с помощью ITIT. (b) Схема стратегии оценки эффективности задач с различной емкостью сети задач. Виртуально окрашенные изображения, а также изображения без меток и изображения, полученные с использованием флуоресцентных изображений, были независимо оценены с использованием сетей задач различной емкости. Источник: Biomedical Optics Express (2025). DOI: 10.1364/boe.576061
В последние годы искусственный интеллект стал невероятно популярен, и многие его сторонники с энтузиазмом рассматривают его потенциальное применение в медицине: например, для быстрой обработки образцов или выявления маркеров заболеваний, которые могут быть неразличимы человеческим глазом. Однако всегда ли применение ИИ — лучший вариант?
Исследователи обнаружили, что, хотя метод виртуального окрашивания на основе ИИ может улучшить использование медицинских изображений в некоторых случаях, в других он может фактически снизить возможность извлечения полезной информации из этих изображений. В целом, они призывают к осторожности при принятии решения о применении ИИ в конкретном рабочем процессе, чтобы убедиться, что он действительно повышает точность по сравнению с другими методами. Исследование опубликовано в журнале Biomedical Optics Express .
«Общий вывод заключается в том, что ИИ может быть отличным инструментом — в некоторых случаях он действительно помогает, — но нужно быть немного осторожнее», — сказал Соурья Сенгупта, аспирант Института передовой науки и технологий Бекмана и ведущий автор данного исследования.
Это исследование было проведено учёными из Центра безметковой визуализации и многомасштабной биофотоники, целью которого является совершенствование технологий визуализации для клинических и исследовательских целей путём разработки новых методов и алгоритмов визуализации. Помимо Сенгупты, в проекте приняли участие исследователи CLIMB Фыонг Нгуен, Фрэнк Брукс, Ян Лю и Марк Анастасио.
Большинство из нас хотя бы раз получали медицинские изображения во время визита к врачу, например, УЗИ, МРТ или рентген. Эти важнейшие инструменты помогают исследователям и врачам диагностировать заболевания, тестировать новые методы лечения и контролировать состояние здоровья пациентов. Другой распространённый класс медицинских изображений — это микроскопические изображения , которые позволяют врачам более детально рассмотреть увеличенные образцы тканей и клеток.
Чтобы улучшить контрастность микроскопического изображения, например, выделить определённую часть клетки, чтобы врачи могли проанализировать её особенности, образцы тканей или клеток часто окрашивают красителями или другими химическими веществами. Несмотря на широкую распространённость, окрашивание может быть длительным и может привести к повреждению клеток.
Визуализация без меток — это альтернатива окрашиванию, при котором к образцу не добавляются химические вещества. Вместо этого исследователи используют естественные свойства биологических материалов для наблюдений и создания изображений. Например, измерение различных путей прохождения света через прозрачные объекты, такие как клетки, даёт нам информацию о плотности и росте клеток.
Однако у этого метода есть и недостатки. Изображения без меток, как правило, менее контрастны, чем изображения с окраской, что может затруднять выявление ключевых особенностей. Для повышения практической ценности и надежности изображений без меток в последнее время появился интерес к новому методу, называемому виртуальным окрашиванием.
В процессе виртуального окрашивания вычислительная модель анализирует изображение без меток и предсказывает, как оно будет выглядеть после окрашивания. В идеале это должно привести к получению изображения с высокой контрастностью, сравнимой с окрашенным, но полученного гораздо быстрее и без риска химического повреждения образца. Однако важно убедиться, что эти виртуально окрашенные изображения действительно точны и полезны для биологических исследований и клинических приложений.
«В медицине или разработке лекарств получение изображений не является конечной целью», — сказал Сенгупта. «В биомедицинской визуализации мы всегда думаем с точки зрения задачи: биологического или клинического применения, которому должны соответствовать изображения. Поэтому мы начали задаваться вопросом: эти изображения, созданные с помощью вычислений, могут выглядеть реалистичными, но действительно ли они помогают в решении реальной задачи?»
Одна из самых сложных задач при поиске ответа на подобные вопросы — это просто наличие достаточного количества данных. Исследователям часто требуются большие наборы парных изображений — одно, полученное без использования меток, и другое, полученное с помощью флуоресцентного окрашивания, — для обучения и тестирования различных моделей искусственного интеллекта. К счастью, команда Лю недавно разработала Omni-Mesoscope — мощную высокопроизводительную систему визуализации, способную захватывать десятки тысяч клеток в различных состояниях за считанные минуты, создавая большие высококачественные наборы данных. Эти наборы данных легли в основу тестирования эффективности виртуально окрашенных изображений в реальных аналитических задачах.
Исследователи сравнили эффективность виртуально окрашенных изображений с изображениями без меток и окрашенными изображениями в двух задачах. Во-первых, изображения использовались в задаче сегментации: процессе, в котором нейронная сеть идентифицирует отдельные ядра клеток и обрезает их, создавая отдельные изображения. Подобно кадрированию фотографии, это позволяет исследователям и врачам сосредоточиться на наиболее важных частях изображения.
Во-вторых, исследователи использовали изображения в задаче классификации клеток, в которой сеть определяла, на каких стадиях развития находятся различные клетки после воздействия препарата. Эта задача применима для мониторинга эффективности препаратов в исследованиях и при лечении заболеваний.
Сравнение изображений двух клеток без метки (первый столбец), виртуально окрашенных (средние столбцы) и флуоресцентно окрашенных (последний столбец). Клетка в нижнем ряду была обработана препаратом, а клетка в верхнем ряду — нет.
В обоих заданиях исследователи оценивали производительность различных сетей при использовании каждого типа изображений. Исследователи хотели выяснить, будет ли относительная эффективность каждого типа изображений меняться в зависимости от свойств используемой сети, поэтому они повторили задания, используя пять различных сетей.
Многие сети выполняют схожие задачи, но некоторые сети могут лучше других представлять сложные функции или взаимосвязи в зависимости от того, как сеть запрограммирована на обучение. Такие сети называются сетями высокой ёмкости. Сети, использованные в данном исследовании, обладали различной ёмкостью, что позволило исследователям увидеть, влияет ли ёмкость на то, как сети используют виртуально окрашенные изображения.
При обработке сетями низкой мощности виртуально окрашенные изображения показали себя значительно лучше, чем изображения без меток. Однако с сетями высокой мощности этого не произошло. При обработке сетями высокой мощности виртуально окрашенные и без меток изображения показали примерно одинаковые результаты. Однако при классификации клеток виртуально окрашенные изображения показали себя значительно хуже. Другими словами, при анализе изображений с помощью сети высокой мощности вы с большей вероятностью получите точную информацию, если будете использовать изображения без меток, а не виртуально окрашенные.
Этот результат согласуется с концепцией, называемой неравенством обработки данных, которая гласит, что обработка любого изображения (например, виртуальное окрашивание) не может увеличить количество содержащейся в нём информации, сказал Сенгупта. Это похоже на ретушь семейной фотографии: можно размыть фон, чтобы выделить людей, но никакое редактирование не откроет глаза тому, кто моргал в момент щелчка затвора.
Сети с низкой ёмкостью, вероятно, полезны для виртуально окрашенных изображений, поскольку обработка может выделить важную информацию. В отличие от этого, сети с высокой ёмкостью, которые уже способны выявлять сложные взаимосвязи на изображениях без меток, неэффективны при виртуальном окрашивании. Процесс виртуального окрашивания может даже удалять информацию, критически важную для некоторых задач, что может объяснять, почему виртуально окрашенные изображения показали худшие результаты, чем изображения без меток в задаче классификации клеток.
Хотя ИИ потенциально применим во многих областях здравоохранения, Сенгупта напоминает врачам, исследователям и всем заинтересованным в этой технологии людям о необходимости учитывать её ограничения. Если ИИ используется для решения конкретной задачи, важно убедиться, что он действительно принесёт пользу в данной ситуации.
«Даже если ИИ сейчас в тренде, нужно быть осторожным, применяя его в таких деликатных областях, как биомедицинская визуализация и здравоохранение», — сказал Сенгупта. «Во многих случаях ИИ очень полезен, но не всегда».
Внимание, автоперевод! За ошибки перевода ответственности не несём. Первоисточник по ссылке.